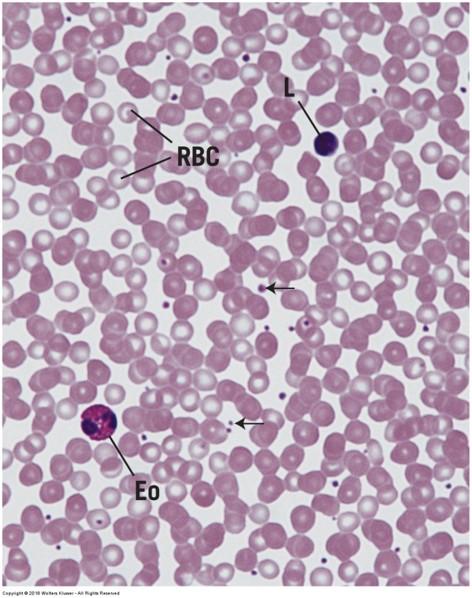

Chapter 3: Connective Tissue

Functions of connective tissue
Support:
- Binds, anchors and supports (structurally and functionally) cells, tissues, and organs
- Glue that holds everything together
Defense:
- Can act as physical barrier
Transport:
- Cells, fluid, and other substances between tissues of the body
Storage:
- E.g. calcium or fat
Repair:
- Scar formation
Connective tissue
- Develops from mesenchyme (mesoderm; embryonic connective tissue)
- Consists of cells and extracellular matrix (ECM)
ECM consists of
- Extracellular fluid (ECF)
- Ground substance (gel-like matrix supporting fibers & cells and allows for diffusion of ECF)
- Protein fibers (collagen, reticular, elastic)
Classification of connective tissue
Based on amount, type, arrangement, and abundance of cells, fibers, and ground substance
Loose: loose, irregular arrangement of fibers in matrix and abundant cells
Dense: thicker more densely packed fibers with fewer cells and less ground substance
- Irregular: random orientation of fibers
- Regular: parallel orientation of fibers
Classification of connective tissue
Embryonic connective tissue
Mesenchyme
Mucus connective tissue
Connective tissue proper
Loose connective tissue
Dense connective tissue
(regular and irregular)
Specialized connective tissue
Cartilage
Bone
Adipose tissue
Hematopoietic tissue (blood, bone marrow, lymphatic tissue)
Connective Tissue Components
Cells
Extracellular matrix (ECM)
- Extracellular fluid (ECF)
- Ground Substance
- Fibers
Cells of connective tissue
Permanent / resident cells
Fibroblasts
- Special names: chondroblasts, chondrocytes & osteoblasts, osteocytes
Adipose cells
Cells with pigmented granules
Migratory cells
- Macrophages
- Mast cells
- Plasma cells
- Other leukocytes

Cells of connective tissue

Resident cells: Fibroblasts

Fibroblasts: fusiform-shaped, synthesize fibers and ground substance (proteins and carbohydrates)
- Elongated cell with cytoplasmic projections
- Ovoid nucleus (typically all that is visible with H & E)
Cartilage = chondroblasts & chondrocytes
Bone = osteoblasts & osteocytes
Resident cells: Adipose cells

- Single cells or groups of cells
When major cell type, connective tissue is called adipose tissue
- store fat (insulation, protection, energy source)
- Narrow rim of cytoplasm
- Flattened off-center nucleus
- Large empty space (dissolved fat)
Migratory cells: Macrophages

- Phagocytic cells
Ingest bacteria, dead cells, cell debris, and foreign material
Antigen presentation
- Found in loose connective tissue
- Round with irregular borders
- Special names: Kupfer cells in liver; osteoclasts in bone; microglia in central nervous system
Migratory cells: Mast cells

- Found near blood vessels in connective tissue of skin, digestive organs, and respiratory organs
- Spherical with fine dark-staining (purple) granules that induce inflammatory responses
- Small central, spherical nucleus
- Synthesize and release heparin and histamine during allergic reactions (anaphylactic reactions & shock)
Migratory cells: Plasma cells

- Lymphocytes that have migrated into connective tissue of respiratory and digestive tracts
- Small cell
- Off-center nucleus with radial clumps of chromatin
- Synthesize and secrete humoral antibodies
- Primary cell type during chronic inflammation

Migratory cells: Other Leukocytes (white blood cells)

- Migrate into connective tissue to produce immune response (defense)
- Lymphocytes: spherical cell with dense purple nucleus; antibodies and cytotoxic reactions
- Eosinophils: bilobed nucleus, large pink/red granules in cytoplasm; parasitic infections and allergic reactions
- Neutrophils: multilobed nucleus, non-staining granules; destroy bacteria
Connective Tissue Components
Cells
Extracellular matrix (ECM)
- Extracellular fluid (ECF)
- Ground Substance
- Fibers
Extracellular matrix: ECF

Fluid component that is similar to plasma
Circulates throughout the ground substance
- Transporting nutrients, oxygen, signaling molecules, carbon dioxide, waste, and blood-borne materials to/from cells
Originates from blood in capillaries and returns to blood through capillaries and lymphatic vessels
Edema

increased ECF and/or cells in any tissue type—common in epithelial & connective tissues
Connective Tissue Components
Cells
Extracellular matrix (ECM)
- Extracellular fluid (ECF)
- Ground Substance
- Fibers
Extracellular matrix: Ground substance
Amorphous, transparent extracellular matrix
Semifluid gel with high water content to allow diffusion of nutrients—due to ECF perfusion
- May be mineralized (bone, cartilage)
- Resistance to compression
Supports, surrounds, and binds all connective tissue cells and fibers
Composed of glycosaminoglycans, proteoglycans, and adhesive glycoproteins (fibronectin, integrins, and laminin)
Extracellular matrix: Ground substance
Gel quality of ground substance slows down flow rate of ECF
- Allows for more time for diffusion of oxygen, electrolytes, nutrients, and metabolites between cells and blood vessels
- Slows down movement of large molecules and pathogens
Connective Tissue Components
- Cells
Extracellular matrix (ECM)
- Extracellular fluid (ECF)
- Ground Substance
- Fibers
Fibers of connective tissue
Amount and arrangement of 3 fiber types depend on function of tissues and organs where they are found
- Collagen
- Reticular
- Elastic
All fiber types produced by fibroblasts
Proteins with long peptide chains

Fibers: Collagen fibers

- Tough, thick, non-branching fibers
- Most abundant fiber type in connective tissue
- Numerous subtypes of collagen fibers
- Stain with eosin (pink)
- Flexible and strong

Skin scar (keloid formation):

increased abundance of collagen fibers replacing normal tissue structures

Fibers: Reticular fibers

- Mainly type III collagen
- Delicate, thin, netlike framework of branching fibers
- Do not form bundles
- Only visible with silver stain (brown to black)
- Liver, lymph nodes, spleen, hemopoietic organs, where blood/lymph filtered
- Support capillaries, nerves, muscle cells

Fibers: Elastic fibers

- Thin, small branching fibers
- Allow stretch (up to 150% resting length)—recoil without deformation
- Less tensile strength than collagen
- Often interwoven among collagen fibers
- Composed of proteins
- Microfibrils and elastin
- Lungs, bladder, skin, aorta, and pulmonary trunk are examples where elastic fibers are prominent
Connective tissue types

Embryonic connective tissue
- Mesenchyme (top panels) and mucus connective tissue (bottom panels)
- Loose and irregular
- Ground substance is semifluid to jellylike
- Numerous fibroblasts (lots of projections)
- Fine collagen or reticular fibers
Loose (areolar) connective tissue

- More prevalent than dense connective tissue
- Loose, irregular fiber arrangement
- Cell density > Fiber density
- Large amount of intercellular space
Main constituents:
- Collagen fibers
- Fibroblasts
- Adipose cells
- Mast cells
- Macrophages

Loose connective tissue

Loose connective tissue

Dense connective tissue
- Thicker and more densely packed collagen fibers vs. loose connective tissue
- Fewer cell types
- Fiber density > Cell density
- Minimal intercellular space
- Less ground substance
Dense irregular connective tissue
- Random and irregular orientation of collagen fibers, interlaced with a few elastic and/or reticular fibers
- Fibroblast is main cell type (occasional macrophages and mast cells)
- Dermis of skin, capsules of organs, and areas needing strong support
- Provides tensile strength and support in many directions
- Resists stretching and tearing
Dense irregular connective tissue

Dense irregular connective tissue

Dense irregular connective tissue

Hypertrophic scars and keloids
Dense regular connective tissue
- Densely packed collagen fibers with a parallel arrangement and very little ECM
- Some ligaments have densely packed, parallel elastic fibers
- Fibroblasts main cell type and line up between fiber bundles
- Tendons and ligaments
- Provide great tensile strength in a single direction
Dense regular connective tissue: longitudinal section


Dense regular connective tissue: longitudinal section


White adipose (unilocular) tissue

- Lipid storage
- Large cells
- Fat is single droplet of triglycerides
- Wide distribution
- Energy source
- Insulation
- Cushions organs
- Highly vascular
White adipose (unilocular) tissue

Brown adipose (multilocular) tissue

- Metabolism
- Smaller cells
- Fat is multiple small droplets
- Heat supply
- Dominate adipose tissue in hibernating animals and infants
- In adults—adrenal glands and vessels in neck or in wasting disease
Cartilage

- Tensile strength
- Structural support for soft tissues
- Flexibility without distortion
- Resists compression
Cartilage has typical connective tissue components
Cells
Extracellular matrix
- ECF + Ground Substance
- Fibers
Collagen often obscured by viscosity of ground substance
Cartilage

Cells
- Chondrocytes and chondroblasts (generate ECM)—cartilage fibroblasts
Extracellular matrix (ECM) (>95% tissue volume)
- Fibers = collagen (individual fibers not visible)
- Ground substance = hyaluronic acid & glycoproteins
Nonvascular: nutrients must diffuse through ECM
Cartilage cells

Mesenchyme cells (during development)
- Differentiate into chondroblasts
- Also form fibroblasts of perichondrium
Chondroblasts
- Divide via mitosis forming isogenous groups and synthesize ECM
Chondrocytes
- Mature chondroblasts surrounded by ECM and located in lacunae
- Maintain ECM
Perichondrium

Found surrounding hyaline and elastic cartilages only
Peripheral layer of vascularized dense irregular connective tissue
- Outer fibrous layer = collagen and fibroblasts
- Inner cellular layer = chondrogenic cells that form chondroblasts
Cartilage matrix

Produced and maintained by chondrocytes and chondroblasts
- Appears glassy
Collagen fibers provide firmness and resilience
- Semi rigid (shock absorber)—soft and pliable
- Chondronectin links cells to fibers in matrix
- Obscured by ground substance
Ground substance associated with fibers
- Sulfated glycosaminoglycans
- Hyaluronic acid
- High water content
Cartilage matrix staining regions

- Ground substance is basophilic but does not stain homogenously --> glycoproteins concentration
- Capsular/ pericellular matrix: ring of more densely stained matrix around the chondrocyte
- Territorial matrix: surrounds the isogenous group
- Interterritorial matrix: outer region that occupies spaces between isogenous groups

Cartilage matrix, cells, and perichondrium

Types of cartilage are distinguished based on amount and types of fibers


Hyaline cartilage

Most common with glassy ECM
Embryos
- Skeletal model for most bones
Adults
- Articular surfaces (joints), end of ribs, nose, larynx, trachea, bronchi
Firm structural and flexible support
Hyaline cartilage and perichondrium: trachea

Osteoarthritis: Erosion of Joint Hyaline Cartilage


Elastic cartilage

Similar in appearance to hyaline cartilage
Matrix has numerous branching elastic fibers in matrix in addition to hyaline cartilage components
- Has perichondrium
- Highly flexible
- Structural support
- Matrix NEVER calcifies!
External ear, walls of auditory tube, epiglottis, and larynx
Elastic cartilage (epiglottis)

Fibrocartilage

Large amounts of dense irregular bundles of coarse collagen in ECM
- Alternating layers of cartilage matrix and collagen bundles
Fibers oriented in direction of stress
Intervertebral disks, symphysis pubis, and certain joints
- Tensile strength, bear weight, resist stretch or compression
No perichondrium
Fibrocartilage (intervertebral disk)

Chondrogenesis

Interstitial growth
- Mitosis of chondrocytes within matrix
- Addition of matrix surrounding new cells
- Increase cartilage size from within
Chondrogenesis

Appositional growth
- At periphery of cartilage
- Chondroblasts differentiate from perichondrium
- New matrix deposited next to existing cartilage
- Increase cartilage width
Bone

Calcified due to mineral deposition in matrix
- Collagen fibers and calcium dominate matrix
Can bear more weight than cartilage
- Rigid skeleton
- Attachments for muscles and organs
- Protects organs
Hemopoeisis (blood cell formation)
Storage of calcium, phosphate, and other minerals
Bone

ECM continually renewed or remodeled
- Mineral needs of body
- Mechanical stress
- Bone thinning (age or disease)
- Fracture healing
Blood calcium regulation
- Parathyroid hormone: increases blood calcium by promoting bone resorption (activate osteoclasts)
- Calcitonin: decreases blood calcium by inhibiting bone resorption (inhibit osteoclasts; activate osteocytes
Bone formation (ossification)
Endochondral ossification
- Cartilage model
- Bones that bear weight
Intramembranous ossification
- No cartilage model
- Flat bones

Endochondral ossification

Way most bones develop
Temporary hyaline cartilage model precedes bone formation
As cartilage model grows and development progresses
- Calcification begins
- Chondrocytes die due to lack of nutrients

Endochondral ossification

Inner perichondrial cells form thin collar of bone around middle of bone shaft
- Now called a periosteum
Osteoblasts secrete osteoid matrix that later calcifies
- Once surrounded cells called osteocytes (located in lacunae)

Endochondral ossification

Osteocytes form cell-cell connections through channels called canaliculi
- Link to blood vessels here as well
Osteoprogenitor cells are also found on inner bone surface (endosteum)
Bone gradually replaces cartilage

Endochondral ossification


Intramembranous ossification

- Mesenchyme cells differentiate directly into osteoblasts—no cartilage precursor
- Osteoblasts produce osteoid matrix which calcifies
- Form and produce network of spongy bone
- Thin rods, plates, and spines of bone matrix called trabeculae
- Osteoblasts change to osteocytes located in lacunae and connected by canaliculi
- Mandible, maxilla, clavicles, and flat bones of skull
Bone cells

- Osteoprogenitor (osteogenic) cells
- Osteoblasts
- Osteocytes
- Osteoclasts
Osteoprogenitor (osteogenic) cells

- Undifferentiated stem cells derived from mesenchyme
- Inner layer of periosteum and entire endosteum
- Continuous source of osteoblasts
Osteoblasts

- Found on surfaces of bone
- Synthesize, secrete, and deposit osteoid matrix
- Calcify bone matrix by releasing vesicles of hydroxyapatite crystals
- Apposed next to growing bone
Osteocytes

- Mature osteoblasts trapped in lacunae
- Smaller than osteoblasts
- Branched with extensions in canaliculi
- Form gap junctions with neighboring cells
- Exchange of nutrients
Osteoclasts

- Large, multinucleated cells
- Bone macrophages
- Where resorption, remodeling, and repair are occurring
Bone matrix

Hard, no diffusion of nutrients
- Highly vascularized
Resists tension and compression
Mostly collagen fibers
Other components
- Sulfated glycosaminoglycans
- Hyaluronic acid
- Osteocalcin and osteopontin
- Hydroxyapatite crystals (calcium phosphate)
Bone types

- Compact bone
- Cancellous (spongy) bone
- Look the same under microscope when stained with H & E!
- Therefore, we use dried sections for compact bone in lab.

Compact bone

Collagen fibers arrange in thin layers of bone called lamellae
- Each lamellae is parallel to adjacent ones
- Form concentric circles around blood vessels
Outer circumferential lamellae
- Just interior to periosteum
Inner circumferential lamellae
- Surround bone marrow cavity (endosteum)
Concentric lamellae
- Surround canals with blood vessels and nerves
- Form unit called osteon (Haversian canal system)
Compact bone

- Lacunae with osteocytes and canaliculi are found between lamellae of osteon
- Volkmann’s perforating canals cross concentric lamellae and connect adjacent osteons
Compact bone


Compact bone


Cancellous (spongy) bone

- Resembles developing bone during intramembranous ossification
- Calcified matrix forms interconnecting trabeculae (spicules) with numerous connected marrow cavities
- Usually sandwiched between layers of compact bone

Cancellous (spongy) bone

Osteogenesis Imperfecta (OI)

Genetically inherited mutation of Collagen Type I genes
- Not only causing brittle bones but also other connective tissue defects
OI decreases bone thickness due to slow bone formation, reduced # trabeculae, thinner trabeculae, & increased bone resorption
Overview of Blood
Fluid connective tissue (ECM = ECF + Ground Substance)
Functions
- Transport nutrients and oxygen to cells
- Transport carbon dioxide and waste away from cells
- Transport of hormones and other regulatory substances to/from cells
- Maintenance of homeostasis (buffer, coagulation, thermoregulation)
- Transport of antibodies and immune cells
Components of blood
Cells (45% volume)—formed elements
- Erythrocytes: red blood cells
- Leukocytes: white blood cells
- Thrombocytes: platelets
Plasma (55% volume)
- Liquid extracellular matrix (ECF + Ground Substance)
- Mostly water
- No fibers
- Gives fluid properties to blood
Blood Cell Types: Appearance

Blood Cell Types: General Features

Erythrocytes
- Enucleated and devoid of typical organelles
- Bind oxygen and carbon dioxide
- Biconcave disk to maximize surface area for gas exchange
- 120 day lifespan
- Stain uniformly with eosin (hemoglobin
Erythrocytes and platelets


Erythrocytes: sickle cell anemia

Leukocytes
Granulocytes: cells containing specific granules
- Neutrophils
- Eosinophils
- Basophils
Agranulocytes: cells without specific granules
- Lymphocytes
- Monocytes
Function outside of blood vessels (defense)
Neutrophils

- Most numerous white blood cell (60-70%)
- 2-3 day lifespan
- Phagocytic
- 10-12 µm diameter
- No characteristic cytoplasmic staining
- Multilobed nucleus
Eosinophils

- Same size as neutrophils
- 10 day lifespan
- Bilobed nucleus
- 2-4% of leukocytes
- Allergic reactions, parasitic infections, chronic inflammation
Eosinophillia in epithelial tissue during parasitic infections or allergic reactions

Basophils

- Rare (< 1%)
- Same size as neutrophils
- Short life span
- Numerous, large, purple granules
- Lobed nucleus
- Vascular disturbances associated with hypersensitivity and anaphylaxis
Lymphocytes

- Most common agranulocyte (20-30% leukocytes)
- Variable lifespan
- Immunocompetent cells
- In transit from one lymphatic tissue to another
- About size of erythrocyte
- Intensely purple stained, indented nucleus (may also be round)
- Thin, pale blue rim of cytoplasm
Lymphocytes: Leukemia

Monocytes

- Largest white blood cell (18 µm diameter)
- 3-8% of leukocytes
- Differentiate in body tissues to macrophages
- Only in blood 3 days
- Indented nucleus (round to horseshoe shape)—kidney bean shape common
- Abundant pale blue cytoplasm
- Act as antigen presenting cells
Thrombocytes:
platelets

- Platelets derived from large polyploid cell (megakaryocyte)
- Small bits of cytoplasm from peripheral area of megakaryocyte break off
- ~2-3 µm
- 10 day life span
- Important for hemostasis (clotting and blood vessel repair)
Human blood smear
Formation of blood cells
Hemopoiesis (hematopoiesis) includes erythropoiesis, leukopoiesis, and thrombopoiesis
Blood cells are continuously produced and destroyed
Formed in red bone marrow and lymphatic tissue of adults
- Yellow bone marrow no longer supports hematopoiesis because marrow is full of fat
Monophyletic theory of hemopoiesis: blood cells derived from a common stem cell
Formation of blood cells
Cell #1: Pluripotential hemopoietic stem cell in red bone marrow is common stem cell
Cell #2 (one of the following):
- Pluripotential myeloid stem cells
Erythrocytes, granulocytes, monocytes, megakaryocytes
- Pluripotential lymphoid stem cells
Lymphocytes
Stem cells undergo numerous divisions and differentiations before mature blood cells are formed
Formation of blood cells


Red bone marrow: reticular connective tissue

Erythropoiesis

1.Pluripotential hemopoietic stem cell
2.Pluripotential myeloid stem cell
3.Proerythroblast
4.Basophilic erythroblast
5.Polychromatophilic erythroblast
6.Normoblast
7.Reticulocyte
8.Mature erythrocyte
Development of granulocytes: part of leukopoiesis

1.Pluripotential hemopoietic stem cell
2.Pluripotential myeloid stem cell
3.Myeloblast
4.Promyelocyte
5.Myelocyte (one of the following):
- 1.Eosinophilic myelocyte --> Eosinophil
- 2.Basophilic myelocyte --> Basophil
- 3.Neutrophilic myelocyte --> Neutrophil
Development of monocytes: part of leukopoiesis

1.Pluripotential hemopoietic stem cell
2.Pluripotential myeloid stem cell
3.Monoblast
4.Promonocyte
5.Monocyte leaves blood à Macrophage in connective tissue
Development of lymphocytes: part of leukopoiesis

1.Pluripotential hemopoietic stem cell
2.Pluripotential lymphoid stem cell
3.Lymphoblast
4.Prolymphocyte
5.Large lymphocyte
- 1.T lymphocyte
- 2.B lymphocyte leaves blood à Plasma cell in connective tissue
Thrombopoiesis

1.Pluripotential hemopoietic stem cell
2.Pluripotential myeloid stem cell
3.Megakaryoblasts
4.Megakaryocytes
5.Platelets
Muscle

Muscle types

Cells are oriented differently in three muscle types.
Functions of muscle tissue
Movement of body and parts of the body
- Skeletal muscle
Change size and shape of internal organs
- Cardiac muscle
- Smooth muscle
Features of all muscle tissue
Aggregates of specialized, elongated cells arranged for mechanical work
Myofilaments are the contractile proteins (clustered into myofibrils)
- Thin filaments: actin
- Thick filaments: myosin II
Special terms for cellular structures
- Cytoplasm = sarcoplasm
- sER = sarcoplasmic reticulum
- Plasma membrane = sarcolemma
- Muscle cell = muscle fiber (NOT same as CT extracellular fiber)
Striated vs. smooth muscle
Striated have stripes that are visible under the light microscope due to the arrangement of myofilaments (sarcomere)
- Skeletal muscle
- Cardiac muscle
Smooth has no stripes because myofilaments are not arranged into sarcomeres
Skeletal muscle

- Elongated, cylindrical cells with multiple nuclei located at periphery of fiber
- Myofibrils extend length of fiber in a regular arrangement
- Cytoplasm stains intensely with eosin (pink/red)
Skeletal muscle- longitudinal section

skeletal muscle-cross section

Skeletal muscle
striations

Skeletal muscle organization: connective tissue sheaths

- Connective tissue (CT) surrounds individual fibers and bundles of fibers (blood and nerve supply)
- Endomysium: reticular fiber layer around individual fibers (cells)
- Perimysium: thicker layer of dense irregular CT surrounding groups of fibers (fascicles)
- Epimysium: sheath of dense irregular CT surrounding all fascicles in the muscle
Skeletal muscle: myofilaments & sarcomere

Each muscle cell is filled longitudinally with repeating arrays of myofilaments called myofibrils
Striations
- A band = dark band
- I band = light band (bisected by Z disc)
Sarcomere = Z disc to Z disc
Duchenne’s Muscular Dystrophy

- Skeletal muscle fibers degenerate and undergo necrosis
- Increased fibrosis in endomysium & perimysium (thicker collagen bundles)
- Leads to progressive muscle weakness
- See also Clinical Considerations 6-1

Skeletal muscle: motor innervation

- Motor neurons branch to synapse with individual muscle fibers
- Synapse called neuromuscular junction (myoneural junction) or motor end plate
Cardiac muscle

- Same arrangement of myofilaments as skeletal muscle
- Striated (sarcomeres)
- Intercalated disks: attachment sites between cells (gap junctions)
- Fibers are variable in length
- Single, centralized nucleus
- Branched fibers
- Spontaneous contractions
Cardiac muscle

Cardiac muscle

Cardiac muscle- longitudinal section

cardiac muscle- cross section

Myocardial Infarction: Heart Attack

smooth muscle

- Bundles or sheets of elongated, fusiform cells with finely tapered ends
- Connected by gap junctions
- Cytoplasm stains evenly with eosin
- Single nucleus in center of cell
- No regular arrangement of actin and myosin (nonstriated)
- Walls of hollow organs and blood vessels
Smooth muscle

Smooth muscle- longitudinal section

smooth muscle- cross section
